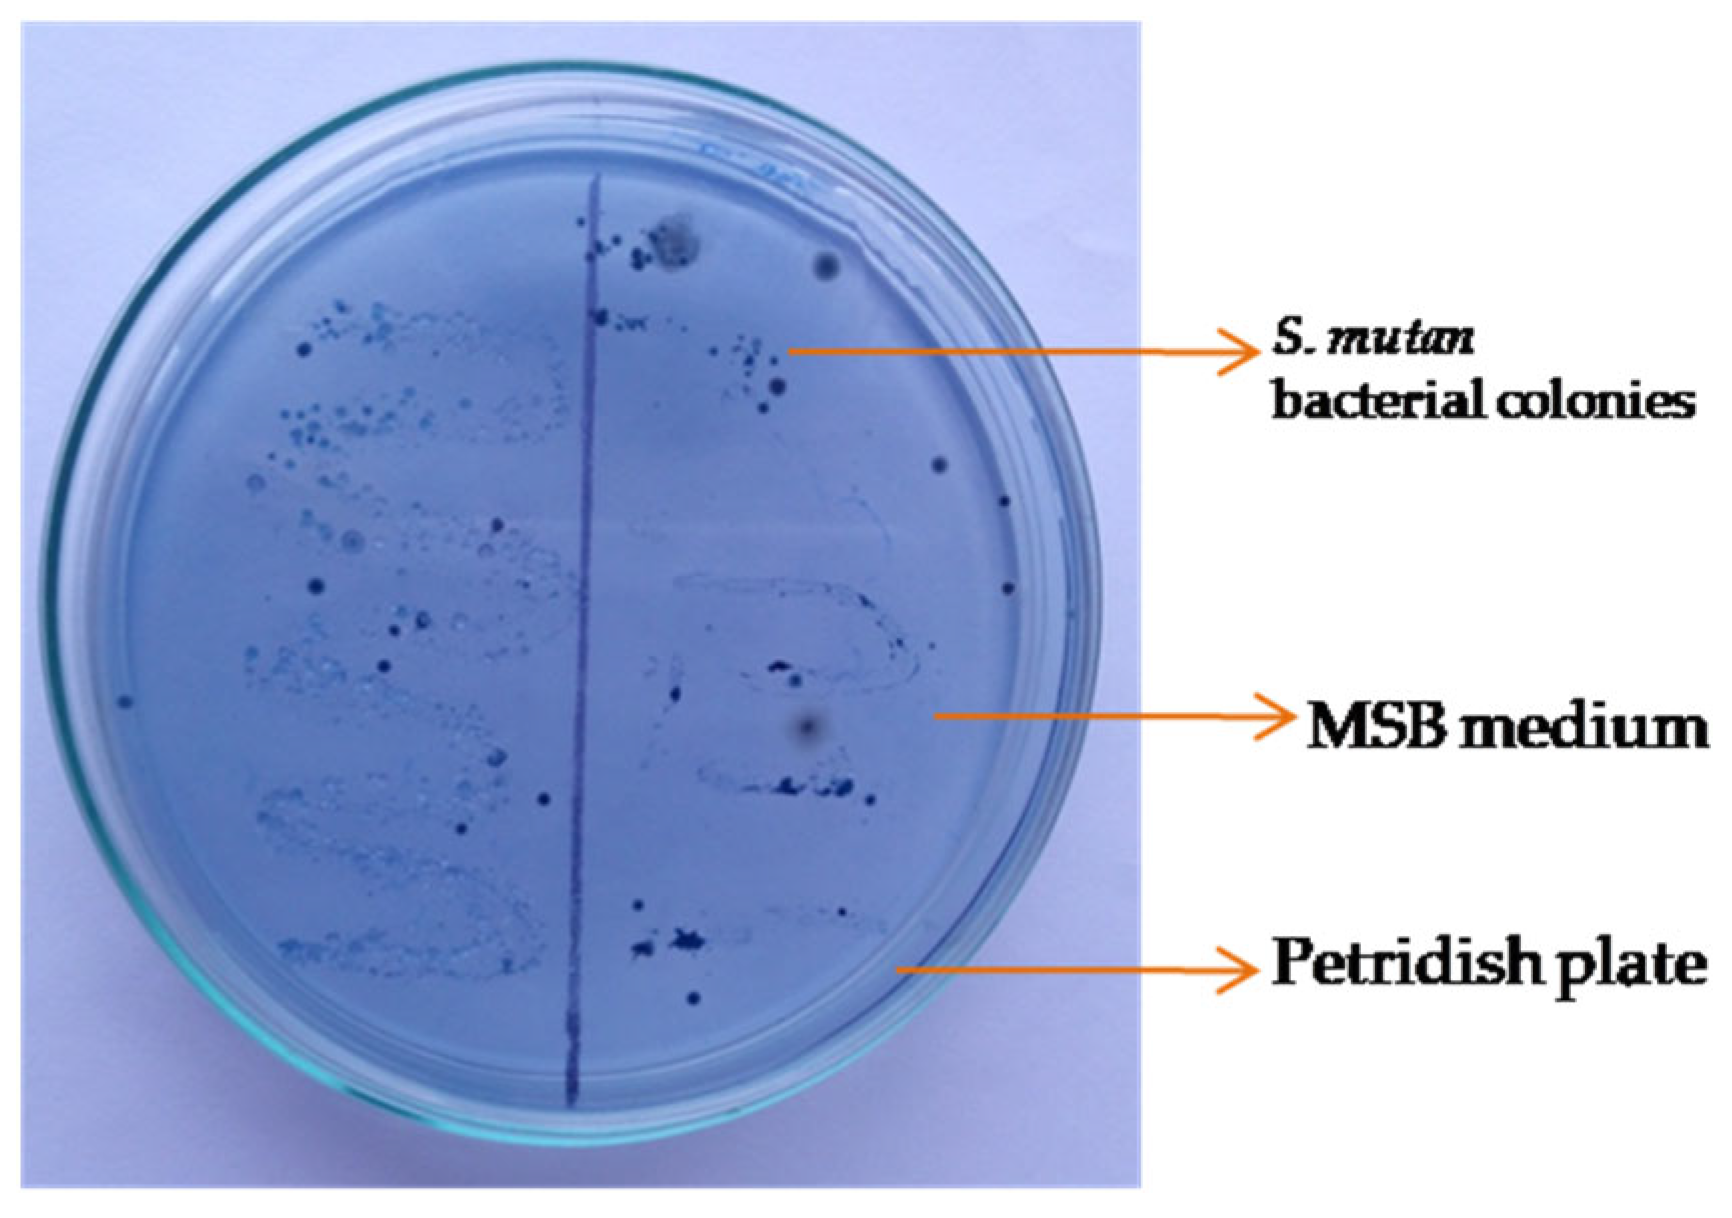
Biomolecules 13 01292 g003

Application of Three Compounds Extracted from Cynodon dactylon against Streptococcus mutans Biofilm Formation to Prevent Oral Diseases
Abstract
:1. Introduction
2. Materials and Methods
2.1. Culture Media
2.2. Collection of Dental Plaque Samples from Patients
2.3. Formation of S. mutans Bacterial Biofilm by Microtiter Plate and Microtiter Spectrophotometric Biofilm Production Methods
2.4. Collection and Preparation of Cynodon dactylon
2.5. Isolation and Purification of Compounds from C. dactylon
2.6. Prevention of S. mutans Biofilm Using Different Compounds Extracted from C. dactylon
2.7. Statistical Analysis
3. Results
3.1. Microbiological Investigation
3.2. Extraction of Compounds from C. dactylon
3.3. Spectral Analysis of the Compounds from C. dactylon
3.4. Patient Status with Dental Plaque and Oral Hygienic Grounds for Biofilm Formation
3.5. Biofilm Formation of Dental Plaque-Causing Bacteria
3.6. Effect of the Plant Extracts on the Growth of Biofilm Formation
4. Discussions
5. Conclusions
Author Contributions
Funding
Institutional Review Board Statement
Informed Consent Statement
Data Availability Statement
Acknowledgments
Conflicts of Interest
Appendix A
| Sl. of Pt. | Age (yrs) | Sex | Dental Plaque Score | Oral Hygiene Condition | Sl. of Pt. | Age (yrs) | Sex | Dental Plaque Score | Oral Hygiene Condition |
|---|---|---|---|---|---|---|---|---|---|
| 1 | 7 | Male | Mild | Good | 51 | 17 | Female | Mild | Good |
| 2 | 5 | Male | Mild | Good | 52 | 11 | Male | Mild | Good |
| 3 | 11 | Female | Moderate | Average | 53 | 10 | Male | Moderate | Average |
| 4 | 8 | Male | Severe | Poor | 54 | 17 | Male | Mild | Good |
| 5 | 23 | Female | Mild | Good | 55 | 35 | Female | Severe | Poor |
| 6 | 10 | Female | Moderate | Average | 56 | 11 | Female | Moderate | Good |
| 7 | 12 | Female | Severe | Poor | 57 | 16 | Female | Moderate | Average |
| 8 | 9 | Female | Mild | Good | 58 | 9 | Male | Mild | Good |
| 9 | 31 | Male | Moderate | Average | 59 | 12 | Male | Mild | Good |
| 10 | 16 | Female | Moderate | Average | 60 | 13 | Male | Mild | Good |
| 11 | 7 | Female | Mild | Good | 61 | 7 | Female | Moderate | Average |
| 12 | 8 | Male | Moderate | Average | 62 | 8 | Male | Mild | Good |
| 13 | 18 | Male | Mild | Good | 63 | 11 | Female | Severe | Poor |
| 14 | 6 | Female | Mild | Good | 64 | 14 | Male | Mild | Good |
| 15 | 15 | Female | Good | Good | 65 | 11 | Female | Moderate | Average |
| 16 | 14 | Male | Moderate | Average | 66 | 22 | Male | Mild | Good |
| 17 | 9 | Male | Severe | Poor | 67 | 18 | Female | Moderate | Average |
| 18 | 8 | Female | Moderate | Average | 68 | 7 | Male | Severe | Poor |
| 19 | 5 | Male | Mild | Good | 69 | 13 | Female | Moderate | Average |
| 20 | 14 | Male | Moderate | Average | 70 | 10 | Female | Moderate | Good |
| 21 | 12 | Male | Mild | Good | 71 | 24 | Male | Mild | Good |
| 22 | 19 | Female | Mild | Good | 72 | 20 | Male | Mild | Good |
| 23 | 7 | Male | Moderate | Average | 73 | 23 | Female | Moderate | Average |
| 24 | 33 | Female | Severe | Good | 74 | 6 | Male | Moderate | Good |
| 25 | 6 | Female | Moderate | Average | 75 | 15 | Female | Mild | Good |
| 26 | 18 | Male | Mild | Good | 76 | 5 | Female | Mild | Good |
| 27 | 5 | Male | Mild | Good | 77 | 16 | Male | Moderate | Average |
| 28 | 30 | Male | Mild | Good | 78 | 9 | Male | Mild | Good |
| 29 | 31 | Male | Moderate | Average | 79 | 34 | Female | Moderate | Average |
| 30 | 17 | Male | Mild | Good | 80 | 10 | Male | Severe | Poor |
| 31 | 13 | Male | Mild | Good | 81 | 37 | Female | Moderate | Good |
| 32 | 26 | Female | Moderate | Average | 82 | 25 | Male | Moderate | Average |
| 33 | 14 | Male | Severe | Poor | 83 | 12 | Male | Mild | Good |
| 34 | 12 | Female | Mild | Good | 84 | 21 | Female | Mild | Good |
| 35 | 36 | Male | Mild | Good | 85 | 8 | Female | Moderate | Average |
| 36 | 22 | Female | Mild | Good | 86 | 27 | Male | Mild | Good |
| 37 | 13 | Female | Moderate | Average | 87 | 14 | Female | Mild | Good |
| 38 | 11 | Male | Mild | Good | 88 | 7 | Male | Moderate | Average |
| 39 | 27 | Female | Mild | Good | 89 | 19 | Male | Mild | Good |
| 40 | 21 | Male | Mild | Good | 90 | 40 | Male | Moderate | Average |
| 41 | 15 | Male | Moderate | Average | 91 | 15 | Male | Moderate | Good |
| 42 | 8 | Female | Mild | Good | 92 | 26 | Female | Mild | Good |
| 43 | 30 | Female | Mild | Good | 93 | 6 | Male | Severe | Good |
| 44 | 7 | Male | Moderate | Good | 94 | 14 | Male | Moderate | Average |
| 45 | 12 | Male | Moderate | Average | 95 | 18 | Female | Mild | Good |
| 46 | 23 | Male | Mild | Good | 96 | 16 | Male | Mild | Good |
| 47 | 18 | Male | Mild | Good | 97 | 16 | Female | Moderate | Good |
| 48 | 20 | Female | Mild | Good | 98 | 10 | Male | Mild | Good |
| 49 | 24 | Female | Mild | Good | 99 | 17 | Female | Moderate | Average |
| 50 | 39 | Male | Moderate | Average | 100 | 9 | Male | Mild | Good |
References
- Liu, M.; Huang, L.; Xu, X.; Wei, X.; Yang, X.; Li, X.; Wang, B.; Xu, Y.; Li, L.; Yang, Z. Copper Doped Carbon Dots for Addressing Bacterial Biofilm Formation, Wound Infection, and Tooth Staining. ACS Nano 2022, 16, 9479–9497. [Google Scholar] [CrossRef]
- Lamont, R.J.; Koo, H.; Hajishengallis, G. The Oral Microbiota: Dynamic Communities and Host Interactions. Nat. Rev. Microbiol. 2018, 16, 745–759. [Google Scholar] [CrossRef]
- Hawas, S.; Verderosa, A.D.; Totsika, M. Combination therapies for biofilm inhibition and eradication: A comparative review of laboratory and preclinical studies. Front. Cell. Infect. Microbiol. 2022, 12, 850030. [Google Scholar] [CrossRef]
- Meng, F.; Zhang, F.; Chen, Q.; Yang, M.; Yang, Y.; Li, X.; Gu, W.; Yu, J. Virtual screening and in vitro experimental verification of LuxS inhibitors from natural products for Lactobacillus reuteri. Biomed. Pharmacother. 2022, 147, 112521. [Google Scholar] [CrossRef] [PubMed]
- Ma, Y.; Shi, Q.; He, Q.; Chen, G. Metabolomic insights into the inhibition mechanism of methyl N-methylanthranilate: A novel quorum sensing inhibitor and antibiofilm agent against Pseudomonas aeruginosa. Int. J. Food. Microbiol. 2021, 358, 109402. [Google Scholar] [CrossRef] [PubMed]
- American Academy of Pediatric Dentistry. Pulp therapy for primary and immature permanent teeth. The Reference Manual of Pediatric Dentistry. Chicago, Ill. Am. Acad. Pediatr. Dent. 2022, 39, 415–423. [Google Scholar]
- Agrawal, R.; Khanduja, R.; Singhal, M.; Gupta, S.; Kaushik, M. Clinical Evaluation of Stainless Steel Crown versus Zirconia Crown in Primary Molars: An In Vivo Study. Int. J. Clin. Pediatr. Dent. 2022, 15, 15–19. [Google Scholar] [CrossRef] [PubMed]
- Watt, R.G.; Daly, B.; Allison, P.; Macpherson, L.M.D.; Venturelli, R.; Listl, S.; Weyant, R.J.; Mathur, M.R.; Guarnizo-Herreño, C.C.; Celeste, R.K.; et al. Ending the Neglect of Global Oral Health: Time for Radical Action. Lancet 2019, 394, 261–272. [Google Scholar] [CrossRef]
- Peres, M.A.; Macpherson, L.M.D.; Weyant, R.J.; Daly, B.; Venturelli, R.; Mathur, M.R.; Listl, S.; Celeste, R.K.; Guarnizo-Herreño, C.C.; Kearns, C.; et al. Oral Diseases: A Global Public Health Challenge. Lancet 2019, 394, 249–260. [Google Scholar] [CrossRef]
- Ray, R.R. Dental biofilm: Risks, diagnostics and management. Biocatal. Agric. Biotechnol. 2022, 43, 102381. [Google Scholar] [CrossRef]
- Engel, A.S.; Kranz, H.T.; Schneider, M.; Tietze, J.P.; Piwowarcyk, A.; Kuzius, T.; Arnold, W.; Naumova, E.A. Biofilm Formation on Different Dental Restorative Materials in the Oral Cavity. BMC Oral Health 2020, 20, 162. [Google Scholar] [CrossRef]
- Albutti, A.; Gul, M.S.; Siddiqui, M.F.; Maqbool, F.; Adnan, F.; Ullah, I.; Rahman, Z.; Qayyum, S.; Shah, M.; Rahman, M. Combating biofilm by targeting its formation and dispersal using Gallic acid against single and multispecies bacteria causing dental plaque. Pathogens 2021, 10, 1486. [Google Scholar] [CrossRef] [PubMed]
- Zayed, S.M.; Aboulwafa, M.M.; Hashem, A.M.; Saleh, S.E. Biofilm Formation by Streptococcus mutans and its Inhibition by Green Tea Extracts. AMB Express 2021, 11, 73. [Google Scholar] [CrossRef]
- Lu, M.; Xuan, S.; Wang, Z. Oral Microbiota: A New View of Body Health. Food Sci. Hum. Wellness 2019, 8, 8–15. [Google Scholar] [CrossRef]
- Cornejo, C.; Salgado, P.; Molgatini, S.; Gliosca, L.; Squassi, A. Saliva Sampling Methods. Cariogenic Streptococci Count Using Two Different Methods of Saliva Collection in Children. Acta Odontol. Latinoam. 2022, 35, 51–57. [Google Scholar] [CrossRef]
- De Faveri, M.; Pupio, G.C.; Koo, H.; Bueno-Silva, B.; de Oliveira, K.M.; Figueiredo, L.C.; Rosalen, P.L.; Hayacibara, R.M.; Fujimaki, M. The effect of Brazilian propolis type-3 against oral microbiota and volatile sulfur compounds in subjects with morning breath malodor. Clin. Oral. Investig. 2021, 26, 1531–1541. [Google Scholar] [CrossRef] [PubMed]
- Wu, R.; Cui, G.; Cao, Y.; Zhao, W.; Lin, H. Streptococcus mutans Membrane Vesicles Enhance Candida Albicans Pathogenicity and Carbohydrate Metabolism. Front. Cell. Infect. Microbiol. 2022, 12, 940602. [Google Scholar] [CrossRef]
- Razuqi, N.S. Biological Effect of Aqueous & Alcoholic Extracts of Green Tea Leaves of Some Pathogenic Bacteria In Vitro. J. Kufa Chem. Sci. 2012, 10, 5–16. [Google Scholar]
- Wang, Y.; Shen, X.; Ma, S.; Guo, Q.; Zhang, W.; Cheng, L.; Ding, L.; Xu, Z.; Jiang, J.; Gao, L. Oral Biofilm Elimination by Combining Iron-Based Nanozymes and Hydrogen Peroxide-Producing Bacteria. Biomater. Sci. 2020, 8, 2447–2458. [Google Scholar] [CrossRef]
- Al-Jumaily, E.F.A.; Al-Seubehawy, H.M.Z.; Al-Toraihy, F.A. Original Research Article Isolation and Identification of Streptococcus Mutans (H5) Produced Glucosyltransferase and Cell-Associated Glucosyltransferase Isolated from Dental Caries. Int. J. Curr. Microbiol. Appl. Sci. 2014, 3, 850–864. [Google Scholar]
- Oliveira, B.E.C.; Ricomini Filho, A.P.; Burne, R.A.; Zeng, L. The Route of Sucrose Utilization by Streptococcus mutans Affects Intracellular Polysaccharide Metabolism. Front. Microbiol. 2021, 12, 636684. [Google Scholar] [CrossRef]
- Aburto-Rodríguez, N.A.; Muñoz-Cázares, N.; Castro-Torres, V.A.; González-Pedrajo, B.; Díaz-Guerrero, M.; García-Contreras, R.; Quezada, H.; Castillo-Juárez, I.; Martínez-Vázquez, M. Anti-pathogenic properties of the combination of a T3SS inhibitory halogenated Pyrrolidone with C-30 Furanone. Molecules 2021, 26, 7635. [Google Scholar] [CrossRef]
- Savadi, S.; Vazifedoost, M.; Didar, Z.; Nematshahi, M.M.; Jahed, E. Phytochemical Analysis and Antimicrobial/Antioxidant Activity of Cynodon dactylon (L.) Pers. Rhizome Methanolic Extract. J. Food Qual. 2020, 2020, 5946541. [Google Scholar] [CrossRef]
- Jalpa, K.; Vijaykumar, R. Extraction and Identification of Phytochemicals in N-hexane and Methanol Extracts of Cocos nucifera L. Leaves. Adv. Zool. Bot. 2023, 11, 213–219. [Google Scholar]
- Nitu, S.; Tarique, H.; Islam, S.M.S. Leaf Epidermal Anatomy of Cynodon dactylon (L.) Pers. in Relation to Ecotypic Adaptation. Bangladesh J. Plant Taxon. 2021, 28, 171–193. [Google Scholar] [CrossRef]
- Mozafari, A.A.; Vafaee, Y.; Shahyad, M. Phytochemical Composition and In Vitro Antioxidant Potential of Cynodon dactylon Leaf and Rhizome Extracts as Affected by Drying Methods and Temperatures. J. Food Sci. Technol. 2018, 55, 2220–2229. [Google Scholar] [CrossRef] [PubMed]
- Biswas, T.K.; Pandit, S.; Chakrabarti, S.; Banerjee, S.; Poyra, N.; Seal, T. Evaluation of Cynodon dactylon for Wound Healing Activity. J. Ethnopharmacol. 2017, 197, 128–137. [Google Scholar] [CrossRef] [PubMed]
- Adikwu, P.; Oyiwona, E.; Johnson, A.; Awua, Y.; Hasan, A.; Adenugba, T.; Ebiega, E. Antibacterial Activity of Psidium guajava Leaf and Stem Bark Extracts on Selected Bacteria in Ugbokolo, Benue State, Nigeria. Adv. Microbiol. 2022, 12, 569–578. [Google Scholar] [CrossRef]
- Kale, S.; Kakodkar, P.; Shetiya, S.; Abdulkader, R. Prevalence of Dental Caries among Children Aged 5–15 Years from 9 Countries in the Eastern Mediterranean Region: A Meta-Analysis. East. Mediterr. Health J. 2020, 26, 726–735. [Google Scholar] [CrossRef]
- Zhang, M.; Han, W.; Gu, J.; Qiu, C.; Jiang, Q.; Dong, J.; Lei, L.; Li, F. Recent advances on the regulation of bacterial biofilm formation by herbal medicines. Front. Microbiol. 2022, 13, 1039297. [Google Scholar] [CrossRef]
- Ahmed, M.; Khan, K.U.; Ahmad, S.; Aati, H.Y.; Ovatlarnporn, C.; Rehman, M.S.; Javed, T.; Khursheed, A.; Ghalloo, B.A.; Dilshad, R.; et al. Comprehensive Phytochemical Profiling, Biological Activities, and Molecular Docking Studies of Pleurospermum candollei: An Insight into Potential for Natural Products Development. Molecules 2022, 27, 4113. [Google Scholar] [CrossRef]
- Subavathy, P.; Thilaga, R.D. GC-MS analysis of bioactive compouns for whole body tissue methanolic extract of Cyprae arabica (K. 1758). World J. Phar. Res. 2016, 5, 800–806. [Google Scholar]
- Tobias, G.; Spanier, A.B. Modified Gingival Index (MGI) Classification Using Dental Selfies. Appl. Sci. 2020, 10, 8923. [Google Scholar] [CrossRef]
- Kolawole, K.A.; Folayan, M.O. Association between malocclusion, caries and oral hygiene in children 6 to 12 years old resident in suburban Nigeria. BMC Oral Health 2019, 19, 262. [Google Scholar] [CrossRef]
- Sharma, R.; Singh, S. Cynodon dactylon (L.) Pers Cow Dung, and Selected Plant Extracts Exhibit Antimicrobial Property Against Cariogenic Streptococcus Species. Int. J. Sci. Res. Sci. Technol. 2017, 3, 688–704. [Google Scholar]
- Shekar, C.B.R.; Nagarajappa, R.; Jain, R.; Shekar, S.; Singh, R.; Thakur, R. Minimum inhibitory concentration of the plant extracts’ combinations against dental caries and plaque microorganisms: An in vitro study. J. Indian Assoc. Pub. Health Dent. 2016, 14, 456–462. [Google Scholar] [CrossRef]
- Nallathambi, A.; Bhargavan, R. GC/MS Analysis of Bioactive Compounds in Aqueous Extract of Cynodon dactylon. Indian J. Public Health Res. Dev. 2019, 10, 55–59. [Google Scholar] [CrossRef]
- Nalini, P.; Prakasham, R.S. Novel, Effective and Sensitive Platz Assay Method for Detection and Screening of Urease Producing Microorganisms. Int. J. Curr. Microbiol. Appl. Sci. 2022, 11, 81–91. [Google Scholar] [CrossRef]

| Name of Compound | Chemical Structure | Molecular Formula | Mol. Weight | R. Time (Min) | Peak Area% |
|---|---|---|---|---|---|
| 3,7,11,15-tetramethyl-headeca-2, 4 dien-1-o1 | ![]() | C20H40 | 280.54 | 27.66 | 80.71 |
| 3,7,11,15-tetramethyl-headeca-2-en-1-o1 | ![]() | C20H40O | 296.53 | 25.33 | 17.10 |
| Stigmasterol | ![]() | C29H48O | 412.70 | 20.5 | 1.64 |
| Degree of Biofilm | Range of OD Values (nm) | Serial Number of Patients | No. of Patients (%) | Mean Value of Biofilm Formation |
|---|---|---|---|---|
| Weak | 0.5–2.0 | 1,2,5,8,11,12,13,14,19,20,21,22,26,27,28,30,31,34,35,36,38,39,40,42,43,46,47,48,49,51,52,54,58,59,60,61,62,64,66,71,72,75,76,78,83,84,86,87,89,92,95,96,98,100 | 54 (54%) | 1.41± 0.53 c |
| Moderate | 2.0–3.5 | 3,6,9,10,15,16,18,23,25,29,32,37,41,45,50,53,56,57,65,67,69,73,74,77,79,81,82,85,88,90,91,94,97,99 | 34 (34%) | 2.79± 0.31 b |
| Strong | 3.5–5.0 | 4,7,17,24,33,44,55,63,68,70,80,93 | 12 (12%) | 3.97± 0.46 a |
| Ethyl Acetate Extract of Compounds | Minimum Inhibitory Concentration (µL/mL) | ||
|---|---|---|---|
| P. aeruginosa | E. coli | Streptococcus mutans | |
| 3, 7, 11, 15 tetramethyl hexadeca-2-4 dien-1-01 | 25.0 | 50.0 | 25.0 |
| 3, 7, 11, 15 tetramethyl hexadeca-2-en-1-01 | 25.0 | 50.0 | 12.5 |
| Stigmasterol | 50.0 | 50.0 | 25.0 |
| Patient No. | Compound | Bacteria | ||||||||
|---|---|---|---|---|---|---|---|---|---|---|
| P. aeruginosa | E. coli | S. mutans | ||||||||
| 12.5 µL | 25 µL | 50 µL | 12.5 µL | 25 µL | 50 µL | 12.5 µL | 25 µL | 50 µL | ||
| Patient No. 17 | T1 | 16.09 a | 31.61 b | 24.42 ab | 14.18 b | 35.96 b | 29.47 ab | 42.96 b | 73.42 a | 70.50 a |
| T2 | 20.98 a | 70.50 a | 34.77 a | 27.93 a | 47.21 a | 38.10 a | 54.61 a | 80.10 a | 76.30 a | |
| T3 | 4.60 b | 18.96 c | 9.48 b | 6.98 c | 19.79 c | 21.79 c | 16.26 b | 26.94 b | 33.50 b | |
| Patient No. 55 | T1 | 19.54 b | 31.82 b | 16.38 b | 13.38 b | 20.76 b | 17.24 b | 23.98 b | 51.35 a | 23.56 b |
| T2 | 33.62 a | 47.41 a | 27.23 a | 26.17 a | 38.52 a | 29.05 a | 39.81 a | 79.74 a | 75.69 a | |
| T3 | 12.64 c | 19.52 c | 12.43 b | 9.91 b | 16.38 b | 11.94 b | 16.45 c | 30.18 b | 19.42 b | |
Disclaimer/Publisher’s Note: The statements, opinions and data contained in all publications are solely those of the individual author(s) and contributor(s) and not of MDPI and/or the editor(s). MDPI and/or the editor(s) disclaim responsibility for any injury to people or property resulting from any ideas, methods, instructions or products referred to in the content. |
© 2023 by the authors. Licensee MDPI, Basel, Switzerland. This article is an open access article distributed under the terms and conditions of the Creative Commons Attribution (CC BY) license (https://creativecommons.org/licenses/by/4.0/).
Share and Cite
Habib, T.; Rahman, A.; Nair, A.B.; Islam, S.M.S. Application of Three Compounds Extracted from Cynodon dactylon against Streptococcus mutans Biofilm Formation to Prevent Oral Diseases. Biomolecules 2023, 13, 1292. https://doi.org/10.3390/biom13091292
Habib T, Rahman A, Nair AB, Islam SMS. Application of Three Compounds Extracted from Cynodon dactylon against Streptococcus mutans Biofilm Formation to Prevent Oral Diseases. Biomolecules. 2023; 13(9):1292. https://doi.org/10.3390/biom13091292
Chicago/Turabian StyleHabib, Tasnia, Aminur Rahman, Anroop B. Nair, and S. M. Shahinul Islam. 2023. "Application of Three Compounds Extracted from Cynodon dactylon against Streptococcus mutans Biofilm Formation to Prevent Oral Diseases" Biomolecules 13, no. 9: 1292. https://doi.org/10.3390/biom13091292
APA StyleHabib, T., Rahman, A., Nair, A. B., & Islam, S. M. S. (2023). Application of Three Compounds Extracted from Cynodon dactylon against Streptococcus mutans Biofilm Formation to Prevent Oral Diseases. Biomolecules, 13(9), 1292. https://doi.org/10.3390/biom13091292




